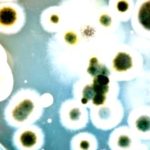
Bacteria: Tiny Life, Big Impact on You

Discover which parts of your body are the biggest, busiest, and most essential for keeping you healthy; from the skin’s protective layers to the brain’s complex control center, explore a surprising size guide to your internal superstars.
Ever wonder which parts of your body are the real MVPs, size-wise? We’re talking about the unsung heroes working tirelessly behind the scenes. And believe it or not, it’s not always what you think! We’re gonna dive into this and, um, yeah, it’s gonna be interesting.
Your body has about 78 organs give or take, all with different shapes, sizes, and functions. But, which organ truly steals the spotlight? Let’s see…
Biggest Organs of the Human Body
Here’s a detailed list of the biggest organs in the human body:
1. Skin
The skin is the largest organ in the human body. It’s our first line of defense, shielding us from the elements and nasty germs, and it’s our external layer, protecting all our internal bits and bobs.
The skin’s made up of multiple layers, including sweat glands, hair follicles and nerve endings.
That said, the skin doesn’t just protect our insides; it also gives us a way to feel the world around us. It’s made of three main layers:
1. Epidermis
This is the outermost layer, packed with cells called keratinocytes. It acts as a barrier between your body and the outside world, preventing harmful substances from getting inside.
This layer also contains melanocytes, which are responsible for producing skin pigment.
2. Dermis
Sitting just below the epidermis, the dermis contains connective tissue, hair follicles, and sweat glands.
3. Hypodermis
This is made up of fat and connective tissue.
The role of the skin as the largest organ in the human body is apparent in:
- Protection.
- Maintaining body temperature.
- Maintaining hydration.
- Getting rid of toxins.
- Vitamin D production.
2. Liver
The liver is one of the largest internal organs in the human body, and it’s also one of the biggest glands. Glands matter, by the way – they’re made up of tissues and cells that help release certain materials that the body uses in different processes.
The average liver weighs between 1.2 and 1.5 kilograms, and it’s located in the upper right part of the abdomen, just below the diaphragm, under the ribs. The liver has two main sections.
For a single minute, roughly 1.5 liters of blood passes through the liver to take part in its functions. And given its importance, the liver’s the main place for storing nutrients.
3. Brain
The brain is one of the biggest organs in the human body. As part of the nervous system, it’s made up of billions of nerve cells, and the brain is divided into several parts, each responsible for a certain set of cognitive functions.
The brain sits inside the skull, which protects it. The skull’s made of 8 major bones. The brain is split into two halves, with each half controlling the opposite side of the body. What does this mean, you ask?
- The right half of the brain controls the left side of the body, and vice versa. The right half controls speech, understanding, calculation, and writing.
- The left half controls creativity, artistic and musical skills, and imagination.
These halves of the brain consist of 4 lobes:
- Frontal.
- Parietal.
- Temporal.
- Occipital.
Each of these lobes is also divided into parts, with each part responsible for specific tasks.
Importantly, these lobes don’t work in isolation; they’re all interconnected.
4. Lungs
The lungs are key organs in the respiratory system. They help us take in oxygen and get rid of carbon dioxide.
The nose and mouth are the main entry points for the respiratory system, as oxygen is inhaled through them and carbon dioxide is expelled.
The nose and mouth lead to the lungs through tubes, and breathing moves air through these tubes and into the lungs. Then the air’s divided into two sections, one for each lung.
5. Heart
The heart is an essential organ in the circulatory system, and it’s one of the most important organs in the human body, second only to the brain.
The heart pumps blood throughout the body. The heart has 4 chambers: the right chambers receive deoxygenated blood, while the left chambers receive oxygenated blood.
There are 3 types of blood vessels in the circulatory system:
- Arteries: Arteries carry oxygenated blood and distribute it to different parts of the body.
- Veins: They receive deoxygenated blood, carrying carbon dioxide and some waste products from the body to the heart.
- Blood capillaries: They’re spread out across many areas of the body.
6. Kidneys
The human body has two kidneys, each weighing about 130 grams for the average adult. Located under the urinary system, the kidneys perform the following functions:
- Receiving blood from the renal artery.
- Filtering out excess salts, water, and waste from the bloodstream.
- Producing hormones, such as rennin and erythropoietin. These hormones play a key role in blood cell production and blood pressure regulation.
“I used to think my stomach was the most important organ because, well, food! But now I realize how much my skin does to keep me safe. It’s like a built-in superhero suit!”
“Honestly, I never gave my liver a second thought until I read this. I knew it was important, but I didn’t realize how much blood it processes every minute. Crazy!”
“Okay, the brain I knew was a big deal, but the way it’s divided into sections and how each side controls the opposite side of the body? My mind is officially blown.”
Myth & Facts
Question: Can your skin completely regenerate?
Not quite like a starfish, but your skin is constantly shedding and replacing cells!
Myth: You only use 10% of your brain.
Nope! You’re using all of your brain, just not all at the same time. Different areas are active depending on what you’re doing.
So, what’s the big takeaway from all this? Well, for me, it’s that we really should appreciate our bodies more. It’s easy to take these “biggest stars” for granted, but they’re all working incredibly hard to keep us ticking. We ought to be grateful!